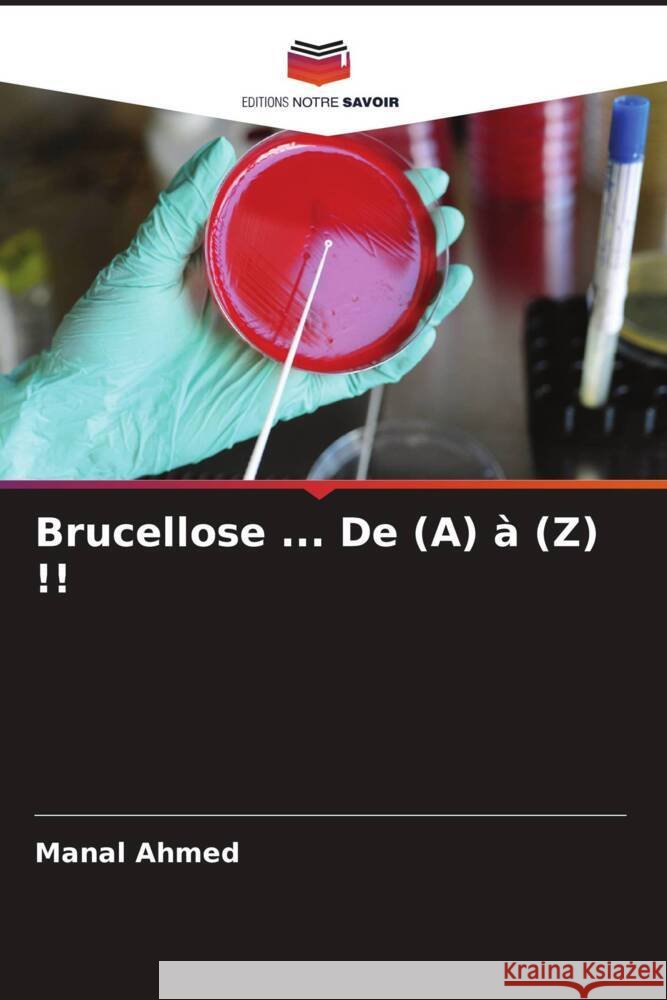
Brucellose ... De (A) à (Z) !! Ahmed, Manal 9786204889368

Wyniki wyszukiwania:
wyszukanych pozycji: 365
 |
Recent advances in bioanalytical approaches for biomarker discovery
ISBN: 9783330006737 / Angielski / Miękka / 2016 / 100 str. Termin realizacji zamówienia: ok. 10-14 dni roboczych. |
cena:
224,25 |
 |
Mulheres no Movimento Islâmico Marroquino al-Adl wa al-Ihsan
ISBN: 9786205442845 / Portugalski / Miękka / 108 str. Termin realizacji zamówienia: ok. 10-14 dni roboczych. |
cena:
273,68 |
 |
Le Moi, l'espace et le temps
ISBN: 9786206710622 / Francuski Termin realizacji zamówienia: ok. 10-14 dni roboczych. |
cena:
273,68 |
 |
The "I", space and time
ISBN: 9786207577002 / Angielski Termin realizacji zamówienia: ok. 10-14 dni roboczych. |
cena:
273,68 |
 |
Poppy Tears
ISBN: 9781504997584 / Angielski / Miękka / 2016 / 108 str. Termin realizacji zamówienia: ok. 16-18 dni roboczych. A compilation of poems mainly around birds and flowers. The poems were written before and after the revolts took place in Egypt and feelings of mixed sadness and loss.
A compilation of poems mainly around birds and flowers. The poems were written before and after the revolts took place in Egypt and feelings of mixed ...
|
cena:
68,85 |
 |
Brucelose ... De (A) até (Z)!!
ISBN: 9786204889375 / Portugalski / Miękka / 168 str. Termin realizacji zamówienia: ok. 10-14 dni roboczych. |
cena:
323,12 |
 |
Government and Society School: Role of Non-Governmental Orginisation in the time of revolution in Egypt
ISBN: 9783656101918 / Angielski / Miękka / 2012 / 70 str. Termin realizacji zamówienia: ok. 16-18 dni roboczych. Professorial Dissertation from the year 2011 in the subject Sociology - Social System, Social Structure, Class, Social Stratification, grade: merit, University of Birmingham (government and society school), course: Human Resouce management and development, language: English, abstract: This research study aims to highlight the roles of NGOs as a part of civil society during the time of revolution or political changes. The study has taken the Egyptian revolution as a case study to answer the questions as to whether NGOs can play any role during the time of a revolution, and what are the NGOs'...
Professorial Dissertation from the year 2011 in the subject Sociology - Social System, Social Structure, Class, Social Stratification, grade: merit, U...
|
cena:
238,12 |
 |
Nicht-newtonsche Eigenschaften von Fruchtkonzentraten
ISBN: 9786203004182 / Niemiecki / Miękka / 2021 / 116 str. Termin realizacji zamówienia: ok. 10-14 dni roboczych. |
cena:
170,32 |
 |
The wear behavior of heat treated Aluminum bronze matrix composite
ISBN: 9783330003651 / Angielski / Miękka / 2016 / 148 str. Termin realizacji zamówienia: ok. 10-14 dni roboczych. |
cena:
251,21 |
 |
Ispytanie ewropeizirowannyh magribinskih älit
ISBN: 9786204500973 / Rosyjski / Miękka / 100 str. Termin realizacji zamówienia: ok. 10-14 dni roboczych. |
cena:
111,45 |
 |
Staphylococcus aureus résistant à la méthicilline
ISBN: 9786204091808 / Francuski / Miękka / 2021 / 132 str. Termin realizacji zamówienia: ok. 10-14 dni roboczych. |
cena:
278,18 |
 |
Zhenschiny w marokkanskom islamskom dwizhenii al'-Adl' wa al'-Ihsan
ISBN: 9786205442890 / Rosyjski / Miękka / 116 str. Termin realizacji zamówienia: ok. 10-14 dni roboczych. |
cena:
111,45 |
 |
Ein Modell für die Bereitstellung von Diensten für das Internet der Dinge durch Telekommunikationsbetreiber
ISBN: 9786202229906 / Niemiecki / Miękka / 2020 / 152 str. Termin realizacji zamówienia: ok. 10-14 dni roboczych. |
cena:
278,18 |
 |
Camel Esterase
ISBN: 9783659213984 / Angielski / Miękka / 2012 / 124 str. Termin realizacji zamówienia: ok. 10-14 dni roboczych. The distribution of esterase isozymes in camel was investigated. The order of esterase activity was liver>lung> kidney> third stomach> intestine> spleen> heart> plasma> red blood cells. Mammalian heart, intestine, kidney, liver, lung, RBC, plasma, spleen, and stomach have 10, 15, 16, 12, 10, 0, 7, 6, and 16 esterase isozymes, respectively. Esterase was isolated from camel liver (LE3) using the following consecutive steps: solubilization with tris/HCl buffer (10 mM, pH 8), precipitation with ammonium sulfate, chromatography on Affi-gel-butyric acid and Affi-gel-oleic acid and preparative...
The distribution of esterase isozymes in camel was investigated. The order of esterase activity was liver>lung> kidney> third stomach> intestine> sple...
|
cena:
265,15 |
 |
Assessment of Changes in Oral Health-Related Quality of Life
ISBN: 9783330650961 / Angielski / Miękka / 2017 / 196 str. Termin realizacji zamówienia: ok. 10-14 dni roboczych. |
cena:
233,24 |
 |
Brucellosi ... Da (A) a (Z)!!!
ISBN: 9786200834362 / Włoski Termin realizacji zamówienia: ok. 10-14 dni roboczych. |
cena:
323,12 |
 |
Le calvaire des élites maghrébines européanisées
ISBN: 9786203434866 / Francuski / Miękka / 2022 / 96 str. Termin realizacji zamówienia: ok. 10-14 dni roboczych. |
cena:
273,68 |
 |
Brucellöz... Ot (A) do (Ya)!!!
ISBN: 9786202520492 / Rosyjski Termin realizacji zamówienia: ok. 10-14 dni roboczych. |
cena:
323,12 |
|
Brucellose ... De (A) à (Z) !!
ISBN: 9786204889368 / Francuski / Miękka / 172 str. Termin realizacji zamówienia: ok. 10-14 dni roboczych. La brucellose est l'une des principales zoonoses causées par le genre bactérien Brucella. Brucella peut être transmise directement ou indirectement de l'animal à l'homme par l'ingestion de denrées alimentaires contaminées, le contact direct avec les tissus d'un animal infecté ou l'inhalation d'aérosols contaminés. Brucella peut être excrétée dans différents fluides corporels comme l'urine, le lait et le liquide placentaire. Elle touche les personnes de tous les groupes d'âge et des deux sexes. La brucellose est une maladie ancienne qui a été connue sous différents noms,...
La brucellose est l'une des principales zoonoses causées par le genre bactérien Brucella. Brucella peut être transmise directement ou indirectement...
|
cena:
323,12 |
 |
Algal Blooms at North Delta Egypt
ISBN: 9783846550076 / Angielski / Miękka / 2012 / 124 str. Termin realizacji zamówienia: ok. 10-14 dni roboczych. |
cena:
265,15 |












